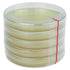

1
/
van
1
Petrischalen met Kimmig Agar (5 stuks)
- Normale prijs
-
€14,50 - Normale prijs
-
- Verkoopprijs
-
€14,50
Inclusief belasting.
Kan ophaalbeschikbaarheid niet laden
Een set van 5 steriel afgesloten petrischaaltjes met Kimmig Agar in een steriele bundelverpakking. Kimmig Fungal Agar wordt gebruikt voor het isoleren en kweken van schimmels uit klinische exemplaren. Het is een niet-selectief medium dat de ontwikkeling van de karakteristieke eigenschappen van mycelium toestaat. Kimmig Agar kan ook worden gebruikt voor de teelt van gisten. De relatief lage pH van de Agar is zeer gunstig voor schimmels en op dit medium worden bacteriën echter slechts zeer weinig geremd.
- Bewaartemperatuur: 2-8 °C (voorkom bevriezing en oververhitting)
- Incubatietemperatuur: 37 °C
- Niet blootstellen aan (direct) zonlicht


Petrischalen met Kimmig Agar (5 stuks)
- Normale prijs
-
€14,50 - Normale prijs
-
- Verkoopprijs
-
€14,50
Voor 12:00 besteld = vandaag verzonden
Gratis verzending in Benelux & Duitsland